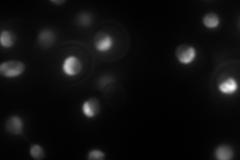
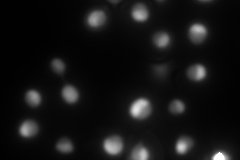

View description
Peptidyl-prolyl cis-trans isomerase (PPIase) (proline isomerase) localized to the nucleus; catalyzes isomerization of proline residues in histones H3 and H4, which affects lysine methylation of those histones
Localization:
Intensity:
Fold change:
Significance:
-
C’ GFP library in SD

nucleus132.81 -
N' NOP1pr-GFP in SD
nucleolus316.354 -
N' TEF2pr-mCherry in SD
nucleus,nucleolus338.434 -
N' NATIVEpr-GFP in SD

nucleus,nucleolus156.802 -
N' TEF2pr-VC and Cyto-VN in SD

#N/A0 -
C’ GFP library in SD+DTT

nucleus93.680.7No -
C’ GFP library in SD+H2O2

nucleus119.630.9No -
C’ GFP library in Starvation Media

nucleus97.510.73No -
C’ GFP library on the background of Pup2-DaMP

nucleus -
C’ GFP library on the background of CCT mutant

nucleus144.3091.0865No
